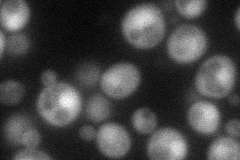
YJR062C
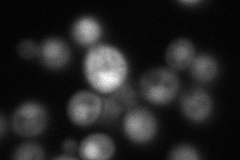
YJR062C
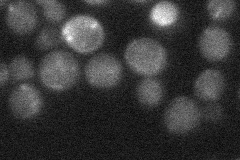
YJR062C
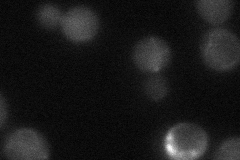
YJR062C
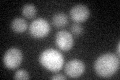
YJR062C

View description
Amidase, removes the amide group from N-terminal asparagine and glutamine residues to generate proteins with N-terminal aspartate and glutamate residues that are targets of ubiquitin-mediated degradation
Localization:
Intensity:
Fold change:
Significance:
-
C’ GFP library in SD

below threshold14.5 -
N' NOP1pr-GFP in SD
cytosol,nucleus52.2964 -
N' TEF2pr-mCherry in SD
nucleus79.1436 -
N' NATIVEpr-GFP in SD
below threshold21.6388 -
N' TEF2pr-VC and Cyto-VN in SD
cytosol33.102 -
C’ GFP library in SD+DTT
cytosol16.61.14No -
C’ GFP library in SD+H2O2

cytosol17.581.21No -
C’ GFP library in Starvation Media

cytosol16.511.13No -
C’ GFP library on the background of Pup2-DaMP

N/A -
C’ GFP library on the background of CCT mutant

N/A0N/AYes
